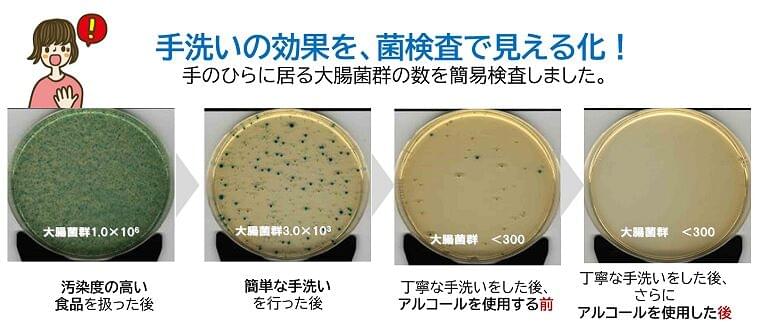

いよいよ6月からHACCPが制度化されました。
そこで今回は、これまでのEatreatアカデミーでいただいた質問の中から、皆さまにも参考となる質問を取り上げてご紹介いたします。
HACCPに取り組みたいけど、周りの理解や協力が得られません
【質問①】
施設の管理栄養士として、衛生管理計画やマニュアル作りを頑張っています。ですが、調理スタッフが従来のやり方から変えることに対し、抵抗があるようです。この温度差、一体どうしたらよいでしょうか。
【回答】
HACCPに取り組むことは、知識が必要なだけでなく、時に職場を巻き込んで仕組みを変えなくてはならないこともあるため、非常にエネルギーのいることですよね。
HACCPへの取り組みは法律で決まったことなので、まずは取り組むことは必須であることを調理スタッフの方々にご理解いただきましょう。
その上で、スタッフの方々が新しい習慣を受け入れやすくなるような仕組みを考えてみましょう。
新しい習慣を受け入れてもらうには、まずはその必要性を理解してもらい、メリットを感じてもらうことが大事かと思います。例えば、一つの手洗いマニュアルがあったとして、「決まりだからとにかくやってください」と言われて実施するのと、マニュアルを遵守することで実際にどれだけ手がきれいになるのか? ということを理解した上で実施するのとでは、どちらがよいでしょうか。この場合、後者の方がよいですよね。
このような必要性とメリットを理解してもらうためには、やはり定期的な衛生管理研修が必要になります。

Eatreatアカデミーでは、菌検査体験ができます。ご興味のある方はぜひご参加ください!
鶏肉のカンピロバクター、家庭での調理が怖いです
【質問②】
Eatreatアカデミーで勉強をし、流通している鶏肉の半数以上に存在するとされるカンピロバクターが、非常に怖いものだと理解しました。仕事でもそうですが、家庭で鶏肉の低温調理などをするのは危険ですか?
【回答】
低温調理の手法がネットなどで広まっていますね。しかし、低温調理には注意が必要です。低温調理をする場合は、参考にするレシピの加熱時間・温度をそのまま鵜呑みにするのではなく、中心温度を測定できる温度計を使って中心温度75℃・1分以上、またはそれと同等(63℃・30分以上)となる方法で加熱しましょう。特に、ポリ袋などを使い低温調理をする場合は、熱の伝わりが遅くなる可能性があるので、中心温度は実測しましょう!
また、衛生的な調理をするには、加熱調理の工程だけ念入りにやっていればよいというものではありません。60℃くらいに冷めたころから増えだす菌もいるので、調理してから提供するまでは、65℃以上あるいは10℃以下の温度帯をキープしましょう。常温放置は厳禁です!
さらに、加熱後の料理を冷蔵庫にしまうときは、必ず粗熱を取ってからにしましょう。なぜなら、冷蔵庫は熱いものを冷やす能力がないからです。また、アツアツのまま入れると庫内の温度が上がり、他の食材の温度管理がめちゃくちゃになってしまいます。粗熱を取る方法としては、「できるだけ小分けにする」「氷水につけて攪拌する」「専用の冷却機器を使用する」などが挙げられます。
サテライトキッチンでの作業に重要管理点がなくてもよい?
【質問③】
セントラルキッチン(以下CK)で調理したものをサテライトキッチン(以下SK)で受け取り、温菜は再加熱してから盛り付けて提供しています。SKでの作業工程に重要管理点が存在しなくてもよいのでしょうか?
【回答】
CKで重要管理点を設定され、SKでの再加熱が加温目的でなければ、SKでの作業に重要管理点がない場合があってもおかしくないでしょう。
ただし、完全調理品を使用する場合、メーカーによってはSKでの再加熱を重要管理点と指定している場合もあるため、メーカーにご確認ください。
※今回の回答は厚生労働省などの公的資料を根拠に回答していますが、衛生管理について迷ったときには、最寄りの保健所にお問い合わせ・確認ください。
HACCPについて気になる方はこちら!
【7/16・オンライン】HACCP&衛生管理講座【基礎編】
参考文献
・厚生労働省:食品等事業者団体が作成した業種別手引書
https://www.mhlw.go.jp/stf/seisakunitsuite/bunya/0000179028_00003.html (閲覧日2021年6月1日)
関連コラム
迫る「HACCPに沿った衛生管理の制度化」求められることはなに?
迫る「HACCPに沿った衛生管理の制度化」②これから取り組むべきこととは
第1回「HACCP」の制度化!準備していますか?
(前編)第2回 HACCPの前提となる「一般的衛生管理」とは?

![山形大 地元農産物で高血圧予防 カリウムで「排塩」 医療費も抑制 [山形県]:朝日新聞](https://s3-ap-northeast-1.amazonaws.com/eat-treat.jp/up/w200/news/11657/11657_0b0bf3ba511150a52f7c949706c4064d.jpg?_t=1782356078)





